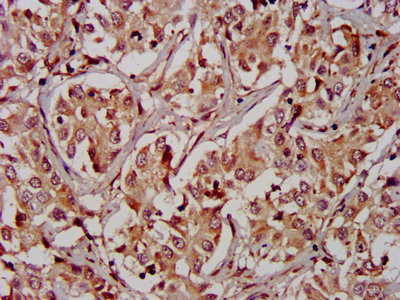

-
中文名稱:RIPK2兔多克隆抗體
-
貨號:CSB-PA019736LA01HU
-
規格:¥440
-
圖片:
-
Western Blot
Positive WB detected in: Rat lung tissue, Rat spleen tissue
All lanes: RIPK2 antibody at 2.7µg/ml
Secondary
Goat polyclonal to rabbit IgG at 1/50000 dilution
Predicted band size: 62, 46 kDa
Observed band size: 62 kDa -
IHC image of CSB-PA019736LA01HU diluted at 1:400 and staining in paraffin-embedded human liver cancer performed on a Leica BondTM system. After dewaxing and hydration, antigen retrieval was mediated by high pressure in a citrate buffer (pH 6.0). Section was blocked with 10% normal goat serum 30min at RT. Then primary antibody (1% BSA) was incubated at 4°C overnight. The primary is detected by a biotinylated secondary antibody and visualized using an HRP conjugated SP system.
-
IHC image of CSB-PA019736LA01HU diluted at 1:400 and staining in paraffin-embedded human placenta tissue performed on a Leica BondTM system. After dewaxing and hydration, antigen retrieval was mediated by high pressure in a citrate buffer (pH 6.0). Section was blocked with 10% normal goat serum 30min at RT. Then primary antibody (1% BSA) was incubated at 4°C overnight. The primary is detected by a biotinylated secondary antibody and visualized using an HRP conjugated SP system.
-
Immunofluorescence staining of Hela cells with CSB-PA019736LA01HU at 1:133, counter-stained with DAPI. The cells were fixed in 4% formaldehyde, permeabilized using 0.2% Triton X-100 and blocked in 10% normal Goat Serum. The cells were then incubated with the antibody overnight at 4°C. The secondary antibody was Alexa Fluor 488-congugated AffiniPure Goat Anti-Rabbit IgG(H+L).
-
-
其他:
產品詳情
-
產品名稱:Rabbit anti-Homo sapiens (Human) RIPK2 Polyclonal antibody
-
Uniprot No.:
-
基因名:
-
別名:CARD 3 antibody; CARD carrying kinase antibody; CARD containing ICE associated kinase antibody; CARD containing IL 1 beta ICE kinase antibody; CARD containing IL1 beta ICE kinase antibody; CARD containing interleukin 1 beta converting enzyme (ICE) associated kinase antibody; CARD containing interleukin 1 beta converting enzyme associated kinase antibody; CARD-containing IL-1 beta ICE-kinase antibody; CARD-containing interleukin-1 beta-converting enzyme-associated kinase antibody; CARD3 antibody; CARDIAK antibody; CCK antibody; CLARP kinase antibody; GIG 30 antibody; GIG30 antibody; Growth inhibiting gene 30 antibody; Receptor interacting protein (RIP) like interacting caspase like apoptosis regulatory protein (CLARP) kinase antibody; Receptor interacting protein 2 antibody; Receptor interacting serine threonine kinase 2 antibody; Receptor interacting serine/threonine protein kinase 2 antibody; Receptor-interacting protein 2 antibody; Receptor-interacting serine/threonine-protein kinase 2 antibody; RICK antibody; RIP 2 antibody; RIP like interacting CLARP kinase antibody; RIP-2 antibody; RIP-like-interacting CLARP kinase antibody; RIPK 2 antibody; Ripk2 antibody; RIPK2_HUMAN antibody; TNFRSF antibody; Tyrosine-protein kinase RIPK2 antibody; UNQ277/PRO314/PRO34092 antibody
-
宿主:Rabbit
-
反應種屬:Human, Rat
-
免疫原:Recombinant Human Receptor-interacting serine/threonine-protein kinase 2 protein (1-540AA)
-
免疫原種屬:Homo sapiens (Human)
-
標記方式:Non-conjugated
本頁面中的產品,RIPK2 Antibody (CSB-PA019736LA01HU),的標記方式是Non-conjugated。對于RIPK2 Antibody,我們還提供其他標記。見下表:
-
克隆類型:Polyclonal
-
抗體亞型:IgG
-
純化方式:>95%, Protein G purified
-
濃度:It differs from different batches. Please contact us to confirm it.
-
保存緩沖液:Preservative: 0.03% Proclin 300
Constituents: 50% Glycerol, 0.01M PBS, PH 7.4 -
產品提供形式:Liquid
-
應用范圍:ELISA, WB, IHC, IF
-
推薦稀釋比:
Application Recommended Dilution WB 1:500-1:5000 IHC 1:200-1:500 IF 1:50-1:200 -
Protocols:
-
儲存條件:Upon receipt, store at -20°C or -80°C. Avoid repeated freeze.
-
貨期:Basically, we can dispatch the products out in 1-3 working days after receiving your orders. Delivery time maybe differs from different purchasing way or location, please kindly consult your local distributors for specific delivery time.
-
用途:For Research Use Only. Not for use in diagnostic or therapeutic procedures.
相關產品
靶點詳情
-
功能:Serine/threonine/tyrosine kinase that plays an essential role in modulation of innate and adaptive immune responses. Upon stimulation by bacterial peptidoglycans, NOD1 and NOD2 are activated, oligomerize and recruit RIPK2 through CARD-CARD domains. Contributes to the tyrosine phosphorylation of the guanine exchange factor ARHGEF2 through Src tyrosine kinase leading to NF-kappaB activation by NOD2. Once recruited, RIPK2 autophosphorylates and undergoes 'Lys-63'-linked polyubiquitination by E3 ubiquitin ligases XIAP, BIRC2 and BIRC3. The polyubiquitinated protein mediates the recruitment of MAP3K7/TAK1 to IKBKG/NEMO and induces 'Lys-63'-linked polyubiquitination of IKBKG/NEMO and subsequent activation of IKBKB/IKKB. In turn, NF-kappa-B is released from NF-kappa-B inhibitors and translocates into the nucleus where it activates the transcription of hundreds of genes involved in immune response, growth control, or protection against apoptosis. Plays also a role during engagement of the T-cell receptor (TCR) in promoting BCL10 phosphorylation and subsequent NF-kappa-B activation. Plays a role in the inactivation of RHOA in response to NGFR signaling.
-
基因功能參考文獻:
- Two Single-Nucleotide Polymorphisms associated with susceptibility to develop dengue in NOD1 or RIPK2 genes were observed Children from Colombia. PMID: 30332343
- Nine compounds from the ZINC database show satisfactory results, yielding among those selected, the compound ZINC01540228, as the most promising RIPK2 inhibitor. After binding free energy calculations, the following molecular dynamics simulations showed that the receptor protein's backbone remained stable after the introduction of ligands. PMID: 30088101
- Results showed that the expressions of RIP2 and BclxL were positively correlated with the malignant grade of astrocytoma. RIP2 promoted human glioblastoma cell proliferation by inducing expression of BclxL. PMID: 29693188
- Together, these data show that RIP2 promotes survival of breast cancer cells through NF-kappaB activation and that targeting RIP2 may be therapeutically beneficial for treatment of TNBC. PMID: 29421659
- RIP2 kinase auto-phosphorylation is intimately coupled to dimerization. PMID: 28545134
- study provides structural and dynamic insights into the NOD1-RIP2 oligomer formation, which will be crucial in understanding the molecular basis of NOD1-mediated CARD-CARD interaction in higher and lower eukaryotes PMID: 28114344
- a new function of PAX5 in regulating RIP1 and RIP2 activation, which is at least involved in chemotherapeutic drug resistance in B-lymphoproliferative disorders, is reported. PMID: 27122187
- this study reveals that LRRK2 is a new positive regulator of Rip2 and promotes inflammatory cytokine induction through the Nod1/2-Rip2 pathway. PMID: 27830463
- Data indicate that receptor-interacting protein 2 (Rip2) polymorphisms are associated with increased risk of subclinical atherosclerosis (SA) and with some clinical and metabolic parameters. PMID: 27939575
- Together, the data demonstrate that the NOD2-RIP2 pathway is activated in murine and human visceral leishmaniasis and plays a role in shaping adaptive immunity toward a Th1 profile. PMID: 27651416
- RIP2 and RhoGDI bind to p75(NTR) death domain at partially overlapping epitopes with over 100-fold difference in affinity, revealing the mechanism by which RIP2 recruitment displaces RhoGDI upon ligand binding. PMID: 26646181
- that Rip2 modifies VEGF-induced signalling and vascular permeability in myocardial ischaemia PMID: 26130752
- up-regulated in failing hearts PMID: 26463597
- NOD2 downregulates colonic inflammation by IRF4-mediated inhibition of K63-linked polyubiquitination of RICK and TRAF6. PMID: 24670424
- RIP2 protein, human is involved in human colon tumorigenesis and could be a predictive marker for colon carcinoma progression PMID: 25374171
- Data indicate that receptor-interacting protein kinase 2 (RIP2) is an activator of the NF-kappa B and c-Jun N-terminal kinase pathways. PMID: 24642040
- NOD1 and RIP2 interact with bacterial peptidoglycan on endosomes to promote autophagy and inflammatory signaling. PMID: 24746552
- the NOD1-RIP2 signaling axis is more complex than previously assumed, that simple engagement of RIP2 is insufficient to mediate signaling PMID: 24958724
- Receptor interacting protein-2 plays a critical role in human lung epithelial cells survival in response to Fas-induced cell-death. PMID: 24658576
- The Nod1/2-Rip2 axis was critical to induce optimal cytokine and chemokine responses to A. baumannii infection. PMID: 24366254
- LRRK2 and RIPK2 variants in the NOD 2-mediated signaling pathway are associated with susceptibility to Mycobacterium leprae in Indian populations. PMID: 24015287
- Our findings identify RIP2 as a substrate for Pellino3 and Pellino3 as an important mediator in the Nod2 pathway and regulator of intestinal inflammation. PMID: 23892723
- In an attempt to explore TRAF3 binding partners that may be involved in TRAF3-regulated signaling, a yeast two-hybrid screen of a human spleen cDNA library was undertaken. RIP2 was identified as a TRAF3 binding partner. PMID: 23333941
- inositol phosphatase SHIP-1 inhibits NOD2-induced NF-kappaB activation by disturbing the interaction of XIAP with RIP2 PMID: 22815893
- RIPK2 might play an important role in hepatic cell migration. These findings could shed new light on carcinogenesis and on liver regeneration. PMID: 22993319
- Association has been found between RIPK2 (rs42490) and cancer risk. PMID: 22504414
- regulates reduced prostaglandin E2 production in chronic periodontitis PMID: 22828789
- RIP2 tyrosine kinase activity is not only required for NOD2-dependent autophagy but plays a dual role in this process. PMID: 22665475
- These findings mechanisms whereby HBeAg modulates intracellular signaling pathways by targeting RIPK2, supporting the concept that HBeAg could impair both innate and adaptive immune responses to promote chronic HBV infection. PMID: 22615316
- IL-4 failed to up-regulate expression of RP105 at the cell surface. In conclusion, the anti-inflammatory actions of IL-4 occur independently of IL-10, RP105, and the kinase activity of RIPK2 PMID: 22484241
- RIP2 gene polymorphisms may be associated with susceptibility to systemic lupus erythematosus in the Chinese population. PMID: 22075569
- GEF-H1 mediated the activation of Rip2 during signaling by NOD2, but not in the presence of the 3020insC variant of NOD2 associated with Crohn's disease. GEF-H1 functioned downstream of NOD2 as part of Rip2-containing signaling complexes. PMID: 21887730
- the CARD of procaspase-1 is differently involved in the formation of procaspase-1 activating platforms and procaspase-1-mediated, RIP2-dependent NF-kappaB activation. PMID: 21862576
- Tri-DAP interacts directly with the LRR domain of NOD1 and consequently increases RICK/NOD1 association and RICK phosphorylation activity PMID: 21757725
- RIP2 polymorphisms are not associated with inflammatory bowel diseases. PMID: 20645315
- RIP2 undergoes autophosphorylation on Tyr 474 and this event is necessary for effective NOD2 signaling PMID: 21123652
- MS80 inhibits CD40-NF-kappaB pathway via targeting RIP2. PMID: 19911254
- detected on all female reproductive tract tissues PMID: 19406482
- Data suggest that inhibition of rip2 upregulation after wounding might contribute to the reduced and delayed wound re-epithelialization phenotype seen in glucocorticoid-treated patients. PMID: 20025869
- Elevated RIP-2 protein levels promote NF-kappaB function via interaction with IKK gamma PMID: 19693652
- the NOD2/RIP2 pathway has a role in recognition of Yersinia, but caspase-12 does not modulate innate host defense against Y. pestis PMID: 19721713
- Involvement of receptor-interacting protein 2 in innate and adaptive immune responses PMID: 11894097
- These results implicate RIP2 in a previously unrecognized role: a checkpoint for myogenic proliferation and differentiation. PMID: 12138198
- equilibrium and kinetic folding of a unique protein domain, caspase recruitment domain (CARD), of the RIP-like interacting CLARP kinase (RICK) (RICK-CARD), which adopts a alpha-helical Greek key fold PMID: 12755636
- role in CARD6 modulation of NF-kappa B activation PMID: 12775719
- Rip2 has an important role in TCR-induced NF-kappaB activation and T-cell function PMID: 14638696
- NOD2-dependent ubiquitinylation of NEMO (a key component of the NF-kB signaling complex) is dependent on the scaffolding protein kinase RIP2. PMID: 15620648
- Caspase-1-mediated cell death is regulated, at least in part, by the balance of Rip2 and Cop; alterations of this balance may contribute to aberrant caspase-1-mediated pathogenesis in Huntington's disease. PMID: 16354923
- CARD6 is a regulator of NF-kappaB activation that modulates the functions of RICK protein PMID: 16418290
- NOD2-S interacts with both, NOD2 and receptor-interacting protein kinase 2 and inhibits the "nodosome" assembly by interfering with the oligomerization of NOD2 PMID: 16492792
顯示更多
收起更多
-
亞細胞定位:Cytoplasm.
-
蛋白家族:Protein kinase superfamily, TKL Ser/Thr protein kinase family
-
組織特異性:Detected in heart, brain, placenta, lung, peripheral blood leukocytes, spleen, kidney, testis, prostate, pancreas and lymph node.
-
數據庫鏈接:
Most popular with customers
-
-
YWHAB Recombinant Monoclonal Antibody
Applications: ELISA, WB, IHC, IF, FC
Species Reactivity: Human, Mouse, Rat
-
Phospho-YAP1 (S127) Recombinant Monoclonal Antibody
Applications: ELISA, WB, IHC
Species Reactivity: Human
-
-
-
-
-